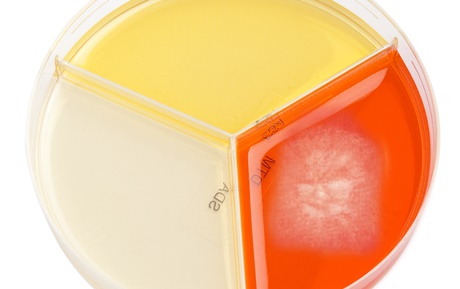
20190308MYKODERMOASSAY TRIO1

메디벳 ˝DTM 한계 극복한 새로운 피부사상균 진단 배지 출시˝
검역본부 허가 받아 MYKODERMOASSAY TRIO 공급 시작
수의임상에서 피부병이 차지하는 비율은 아주 높다. 그중에서도 피부사상균(Dermatophyte, 피부진균, 링웜)에 의한 피부질환은 임상적으로 중요하다고 평가받는다. 인수공통전염병이므로 진료를 하는 수의사는 물론 동물과 함께 지내는 보호자도 주의해야 하기 때문이다. 이러한 피부사상균의 진단은 간단하고 편리한 배지를 이용하는 경우가 대부분이다.
메디벳(대표 이도규)은 최근 피부사상균 진단에 많이 사용하는 기존 DTM(Dermatophyte test medium)의 한계를 극복한 ‘MYKODERMOASSAY TRIO’를 농림축산검역본부의 허가를 받아 국내에 독점으로 공급한다고 발표했다.
메디벳은 “MYKODERMOASSAY TRIO는 하나의 페트리접시에 DTM뿐만 아니라 ESA(Enhanced sporulation agar) 와 SAB/SDA(Sabouraud agar)를 포함시켜 보다 정확하게 피부사상균을 확인할 수 있을 뿐만 아니라 다른 진균도 배양할 수 있다”고 설명했다.
이어 “DTM은 피부사상균이 증식하면 배지의 색깔이 오렌지색에서 빨간색으로 변하므로 감염 여부를 확인할 수 있는 배지다. 단점은 피부사상균 외의 다른 균에 의해서도 배지의 색깔이 변한다는 점”이라고 덧붙였다.

이어 “ESA는 포자의 형성을 촉진하는 배지로써 피부사상균이 증식하면 배지의 색깔이 노란색에서 청록색으로 변하므로 감별할 수 있으며, 배지 그대로 위와 아래에서 현미경으로 포자를 관찰할 수 있게 되어 있다. 특히 피부사상균이 아니면서 DTM에서 양성으로 나오는 경우가 있는 데, ESA로 이를 감별할 수 있어서 진단율을 높일 수 있다”고 강조했다.
SAB/SDA는 보편적인 진균 배지로 피부사상균을 비롯하여 모든 진균을 배양할 수 있다. 때문에 여러 검체의 진균감염에 유용할 것으로 보인다.
제품 설명서의 배지 종류와 해석은 위 표와 같다.
메디벳 대표 이도규 수의사는 “임상에서 많이 만나는 피부사상균의 진단율을 높여 환자의 치료율이 증가하여 삶의 질이 개선되고, 예방 차원의 효과도 기대된다”고 평가했다.
제품에 대한 자세한 사항은 메디벳 대표(이도규) 번호 010-2419-0075로 문의할 수 있다.